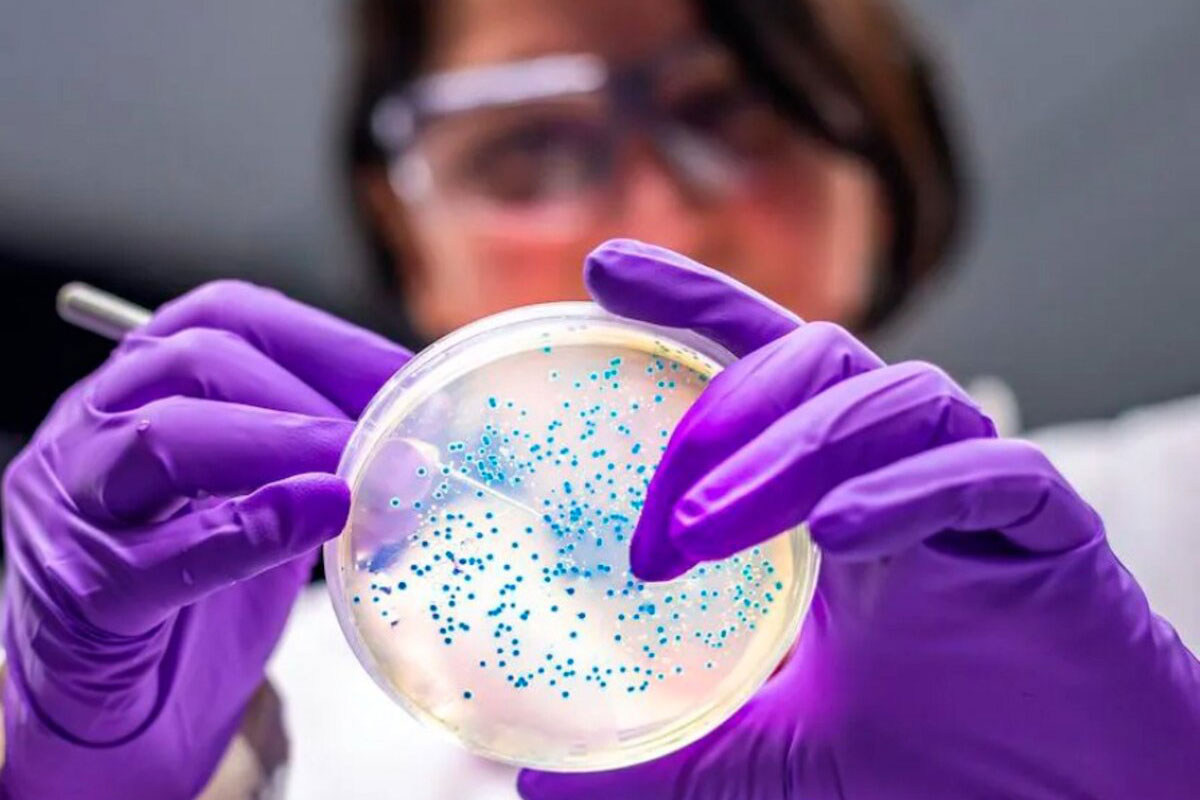

Se acaba de publicar el trabajo más completo y extenso hasta ahora sobre la transmisión de bacterias intestinales y de la boca entre generaciones y entre personas que viven en contacto estrecho. Y la conclusión se resume en una frase: heredamos bacterias de nuestra madre y las compartimos en nuestro círculo más cercano.
En el estudio han colaborado 43 investigadores procedentes de 18 centros de investigación de una decena de países, entre ellos la Argentina, a través del Instituto de Lactología Industrial (CONICET-UNL) de la Facultad de Ingeniería Química de la Universidad Nacional del Litoral (en el caso de nuestro país se analizó la relación de bebés menores de un año con sus madres en pueblos rurales de Santa Fe como Las Arenas, y Pozo Borrado).
Su análisis se basa en más de 9 000 muestras de heces y saliva de madres e hijos, nonagenarios (entre 94-105 años) y sus descendientes, voluntarios sanos que conviven juntos en la misma casa, familias completas, grupos de gemelos…
Para identificar a los microorganismos se han empleado técnicas de metagenómica. Para entender cómo funciona, imaginemos por un momento que digo una frase, solo una, para que identifiquen el título del libro al que pertenece y su autor. Si pronuncio “En un lugar de la Mancha…”, muchos sabrán que hablo de la novela El ingenioso hidalgo don Quijote de la Mancha, escrita por Miguel de Cervantes Saavedra. Los más listos incluso serán capaces de ponerle fecha: escrito entre los siglos XVI y XVII. Y todo a partir de solo seis palabras. No necesitamos leer el libro entero para saber eso.
De manera similar, las técnicas de metagenómica permiten detectar e identificar qué bacterias hay en la muestra, concretando hasta el tipo de cepa, sin necesidad de cultivarlas en el laboratorio: solo leyendo un pedacito de la información que contiene su ADN.
Un tercio de las bacterias que intercambiamos ni siquiera tiene nombre
Ya sabíamos que heredamos bacterias de nuestra madre en el momento del parto. Y que, como la leche materna no es ni mucho menos estéril, nos seguimos nutriendo de bacterias durante la lactancia. Sabíamos también que compartimos bacterias entre nosotros y que cada uno posee una microbiota única que nos distingue unos de otros. Pero hasta ahora todos estos resultados se habían obtenido con un número de muestras muy limitado.
Los autores del nuevo estudio han caracterizado y cuantificado el patrón de transmisión de bacterias, de persona a persona y en distintos escenarios, para entender exactamente cómo las intercambiamos. Lo primero que les ha llamado la atención es que el 37 % de todas las cepas detectadas corresponden a genomas de bacterias desconocidas, que no somos capaces de cultivar en el laboratorio y que ni siquiera tienen nombre. Es como si nos perdiéramos la información de más de un tercio de la novela: está escrita, pero no sabemos su significado.
Es evidente que todavía nos queda mucho por descubrir del mundo microbiano que habita en nuestro interior.
Un 12 % de bacterias compartidas viviendo en la misma casa
Los bebés de 0 a 3 años comparten con sus madres un 34 % de las bacterias, un porcentaje que aún es mayor durante el primer año de vida en los bebés que han nacido por parto vaginal.
Algunas bacterias se transmiten con mayor frecuencia de madres a hijos, como por ejemplo Bacteroides vulgatus y Bifidobacterium longum. Después de los tres años, esa tasa de bacterias compartidas va disminuyendo hasta acabar siendo similar al de las personas que viven juntas.
Pero no hay solo transmisión vertical de bacterias de la madre al bebé. También juega un papel esencial en la composición de nuestra microbiota la transmisión horizontal, es decir, entre convivientes y vecinos. Cuanto más tiempo pasan juntas las personas, más bacterias comparten, sobre todo bacterias de la saliva.
El estudio estima también que los mayores de cuatro años que viven en la misma casa comparten un 12 % de las bacterias. Por su parte, los adultos que no habitan juntos, pero viven en el mismo pueblo, comparten un 8 %. Con la edad ese efecto es menor, lo que confirma una mayor resistencia a la colonización en personas mayores.
Se observa también que los gemelos adultos que no habitan juntos comparten también un 8 %, aunque esa tasa disminuye conforme pasan más años separados. En el caso de los gemelos, existe un efecto genético moderado, ya que los gemelos idénticos (monocigóticos) tienen tasas ligeramente más altas.
Las bacterias que más intercambiamos coinciden con las observadas entre madres e hijos, lo que sugiere que los géneros Bacteroides y Bifidobacteriumson son supertransmisibles, independientemente del modo de transmisión.
¿Significa eso que se transmite el cáncer?
Por el contrario, el porcentaje de bacterias compartidas entre personas que viven en pueblos distintos es prácticamente inexistente. Cuando se comparan poblaciones distintas que no tiene ningún tipo de contacto o relación entre ellas, el porcentaje de individuos que no comparten ninguna bacteria es del 97 %. Es lo que se conoce como tasa de bacterias no compartida, y confirma que compartimos bacterias con nuestros parientes, las personas con las que convivimos o nuestros vecinos, siempre que haya contacto.
Lo interesante del asunto es que la composición y la diversidad de la microbiota influyen en nuestra salud. Entender cómo compartimos algunas bacterias entre nosotros es fundamental para controlar ciertas enfermedades. Este nuevo trabajo refuerza la hipótesis de que algunas enfermedades que consideramos no transmisibles pero que sabemos que están influidas por la microbiota, como el cáncer o la depresión, podrían tener un cierto grado de transmisibilidad.
*Artículo publicado por Ignacio López-Goñi en el sitio de divulgación científica The Conversation.